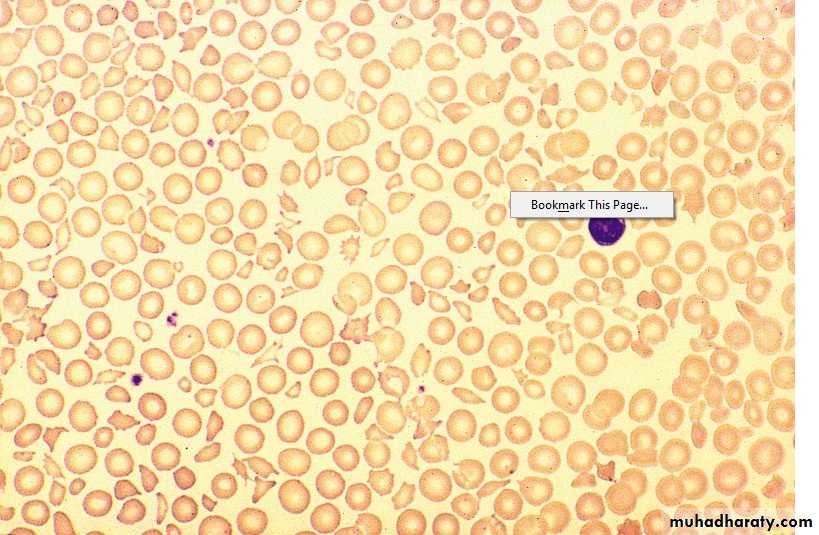

Haematology
Dr Khudhair Abass AliCollege of Medicine – Baghdad University
Objectives Lecture 2
1.Thrombotic thrombocytopenic purpura.2.Thrombocytosis.
3.Platelets function disorders.
4.Vessel wall abnormalities.
Hereditory haemorrhagic telengiectasia.
Henoch shonlein purpura.
Thrombotic Thrombocytopenic Purpura (TTP) (HUS)
Aetiology : Autoimmune disorder, mediated by Abs. against ADAMTS – 13 enzymes .(This enz. normally clears VWF multimers to produce normal functional units and its deficiency results in large VWF multimers which cross – link platelets and leads to microvascular occlusion by plat. Thrombi e.g. brain, kidney).
Idiopathic, associated with drugs (Ticlopidine, Ciclosporine), HIV, Malignancy.
Clinically : Sporadic, Fluctuating, Familial: reported, F > M , young – adolescent
1. Fever
2. Anemia : Microangiopathic haemolytic (Fragmented RBCs) ,
↑ Reticulocyte count, Jaundice, ↑ LDH, -ve coomb’s test.
3. Thrombocytopenia – Purpura, count usually < 20 X 109 /L
4. Neurological: Convulsion, Coma, Paralysis ( Transient or prolonged) ,
Psychological .
5. Renal : intermittent proteinuria, Renal Failure (more in HUS)
Lecture (2)
Lab. ↑ WBC, ↓ plat.
PT, PTT ------- NormalB.M. ------- Normal or increase cellularity
Gingival Biopsy – Helpful
DD : ITP
Prognosis : 10% Recurrent.Untreated – 90% Mortality in 10 days
Treated – Mortality 20-30% at 6 months
Sudden death due to cardiac Micro thrombi
Treatment : Plasmapharesis with FFP 12 bags/day for weeks – Months
Corticosteroids, Rituximab have a role.Pregnant – May needs termination if no response
Plat. Function disorders
1. Acquireda. Iatrogenic
Aspirin – Cyclo – Oxygenase inhibitor
Clopidogrel – ADP receptor inhibitor
Abciximab – Gp 11 b / 111 a inhibitor
Tirofiban – Gp 11 b / 111 a inhibitor
Dipyridamol – phosphodi esterase inhibitor
b. Antibiotics: Penicillin, Cephalosporines
c. Heparin
d. CRF
e. Myelofibrosis
f. Paraproteinaemia
g. CTD
2. Congenital
a. Glanzmann’s thromboasthenia - Def. of GP 11b / 111a
AR, bleeding variable, often severe.
b. Bernard – Soulier dis. def. of GP 1b. AR
c. Defective plat. Granules – deficiency of dense granules
(b & c cause mild bleeding e.g. after trauma or surgery, rarely spont.)
Management :
Local mechanical pressure .Antifibrinolytic e.g. Tranexamic acid may be useful .
Plat. Transf. in severe bleeding.
Recombinant FVIIa in resistant bleeding in Glanzmann's.
VESSEL WALL ABNORMALITIES
1. Hereditary: HHT, EDD, Osteogenesis imperfecta2. Inflammatory: Bacterial, Viral, Vasculitis.
3. Abn. Collage: Senile, Scurvy, Steroids.
4. Metabolic : Liver disease, Renal, Amyloidosis.
5. Others: Factitious, Paraproteinaemia, Drugs.
Hereditary Haemorrhagic Telengiectesia (HHT)
(Osler – Rendu – Weber synd.)
Clinically := A.D., Telengiectasia and small aneurysms on Fingers, lips, Face,
Tongue, Nasal passages, Lungs, G.I.T. / Usually appear at adulthood.
Signif. No. have Pulmonary. A.V. malformation (PAVMS) → Arterial
Hypoxaemia due to Rt. To It. Shunt → paradoxical embolism →
stroke or cerebral abscess.
Recurrent Bleeding e.g. Epistaxis or Malaena → Fe def. An.
Treatment : Deficult because. Of multiple Bleeding sites.
Regular Fe therapy
Local Cautary or Laser, Oestrogens ?
Ehlers – Donalos Dis :
AD. , Collagen defectFragile Bl. Vessel. And organ membrane. → Bleeding and organ rupture
Joint Hypermobility
Scurvy
. Vitamin C def. → affect normal synthesis of collagen. Perifollicular and patechial haemorrhage, sub- periosteal bleeding
. Diagnosis : Dietary History
Henoch – Schonlein Purpura (HSP)
. Children and young adults .
. Immune complex deposition in small vessel. With vasculities .
Often preceded by upper resp. inf.
Clinically :
1. Purpura: (raised) Buttocks and legs
2. Abdominal colicky pain and bleeding
3. Arthritis : Knees, Ankles .
4. Nephritis : 40% (May be later – 4 wks.)
Diagnosis : Clinical, Tissue biopsy ( IgA deposition in bl. Vessel.)
Prognosis : good, Adverse if HTN, RF, Proteinuria > 1.5 g / day
Treatment : Nonspecific
Steroids for joint or GI involvement
Nephritis – pulse iv steroids ± immunosuppressors.
Thrombocytosis
1. Reactive (most Common) 2. Clonala. Chr. Infl. Dis. E.g. ulc. Collitis a. Pri. Thrombocythaemia (ET)
b. CTD e.g. Rh. Arthritis. b. PRV
c. Malignancy e.g. Hodgkin’s dis. c. Myelofibrosis.
d. Acute Haemolysis d. CML.
e. Fe. Def. An. e. MDS.
f. GI bleeding
g. Post – splenectomy
Clinically :
Those of the underlying dis.
Haemostasis rarely affected
PRV, ET, Myelofibrosis, may present with thrombosis and rarely bleeding
Reactive : No splenomegally.
Summary
TTPAutoimmune.
Clinically: 1.Fever
2.Microangiopathic haemolytic An.(Fragmented RBC)
3.Low plat.
4.Neurological.
5.Renal.
R: FFP + Plasmapharesis.
Thrombocytosis: Reactive or clonal.
Platelet function disorders: Acquired or congenital.
Vessel wall abnormalities : HHT, HSP